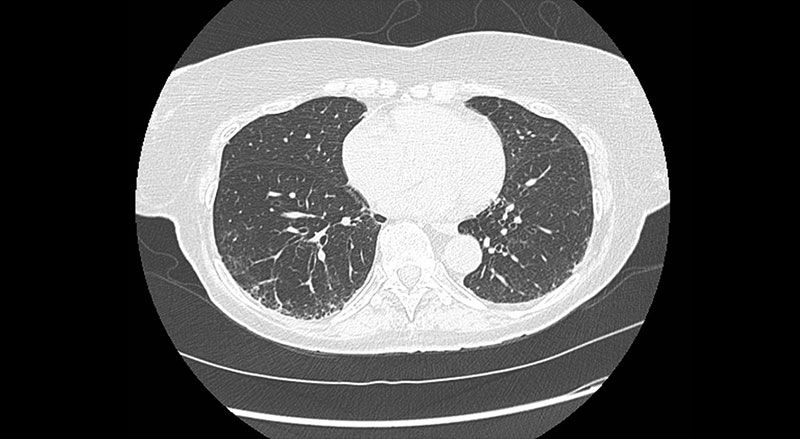

At NewYork-Presbyterian/
Dr. Podolanczuk oversees one of only a few programs in the country focused on identifying ILAs before they progress to ILD or pulmonary fibrosis. ILAs often present without symptoms and are found on imaging incidentally.
Traditionally it’s been very hard to identify patients with early stages of disease. As a result, patients have generally been diagnosed with ILDs when their disease is advanced and there are few interventions to improve their quality of life at that point.
— Dr. Anna Podolanczuk
“Typically patients don’t have symptoms. They’re getting a CT scan for another indication. That’s what defines ILAs,” Dr. Podolanczuk says. “Sometimes if you probe the patient closely, you might find that they have true ILD, it just has not been diagnosed before. A lot of these patients haven’t been told about these findings or have been told that they’re nothing to worry about. In my approach, I comprehensively evaluate them and then decide on appropriate follow up and management approach. It is on us to fully evaluate them.”
She adds that often, patients blame their symptoms on aging. “A lot of patients will say they’re getting more short of breath because they’re getting old,” Dr. Podolanczuk says. “You realize that’s not what it is, that it’s actually being caused by underlying disease.”
Identifying and Risk Stratifying Patients with ILAs
ILAs can lie dormant for long periods of time before progressing to ILD, and some may never progress. Unfortunately, there are currently no treatments that can reverse disease once it develops. However, Dr. Podolanczuk states the importance of mitigating risk when possible. “We do a full interstitial lung evaluation and ask them about exposures and risk factors for ILD, including a lot of environmental factors that can cause ILD,” she says. “There are a lot of things we can do to decrease the risk of progression and mitigate some of the risk factors that can contribute to fibrosis.”
Dr. Podolanczuk risk stratifies patients in her clinic based on a comprehensive and protocolized approach, consisting of lab workups, patient history, and image findings from CT scans. Patients are categorized into low-, medium-, or high-risk categories. If they are high risk, they are monitored closely or even immediately diagnosed with ILD. “This is a slow progressive disease, but sometimes it progresses more rapidly depending on the imaging patterns and extent of the abnormalities, and we can use these to risk stratify them,” she says. “For some patients, we might see them every six months to do pulmonary function tests and assess symptoms. If we see that any of those numbers are dropping, that would be assign that they’re having disease progression.
CT image showing ILA with early signs of fibrosis identified through lung cancer screening
Risk factors can include things like mold, smoking, and occupational exposures. “Sometimes we find that people have mold in their house and that is actually driving these findings,” says Dr. Podolanczuk. “If they get rid of the mold, that can sometimes arrest the process. There’s a lot of risk factor mitigation. We monitor them very closely, and if there are signs of progression [to true ILD], then we can initiative disease modifying treatments early on.”
Dr. Podolanczuk says that the management of ILAs and ILDs must be individualized. “We need to take an individual approach to evaluation and management of these patients,” she says. “It’s not one-size-fits-all. Antifibrotics may be right for one patient but not for another. For example, there’s a difference between a 65-year-old who wants to keep hiking and an 85-year-old who is home bound. Yes, the medications will slow disease progression in both patients, but the side effects may not be worth it. That individual approach is important.”
We need to take an individual approach to evaluation and management of these patients. It’s not one-size-fits-all.
— Dr. Anna Podolanczuk
Research to Understand ILAs and Disease Progression
Research plays a big role in Dr. Podolanczuk’s management of ILAs, particularly around early detection and ultimately prevention of pulmonary fibrosis. She works closely with Fernando J. Martinez, MD, MS, Chief of the Pulmonary and Critical Care Medicine at NewYork-Presbyterian/
Genetic risk is one area of research that she is particularly interested in. “We’re interested in first-degree relatives who are at increased risk for pulmonary fibrosis,” says Dr. Podolanczuk. “We may recommend genetic evaluations to help us better identify or predict patients who are going to progress to fibrosis. This [commitment to research] is unique to our program and not widely available at other centers.”
One area of research that needs to be focused on is prevention. “I think there’s enough data now in terms of who is at high risk for developing ILD and who is at high risk for progression to pulmonary fibrosis to put together a cohort of individuals and start planning interventions,” Dr. Podolanczuk says. “However, we need a roadmap for how to design clinical trials that focus on prevention.”
She recently served as the senior author on a paper outlining a potential approach to clinical trials for the prevention of pulmonary fibrosis. In the paper, which was published in September in the Annals of the American Thoracic Society, she and the other authors, including Dr. Martinez, "summarize methods to identify the target population for a preventative clinical trial; propose a framework for an approach to a clinical trial that tests therapeutic interventions to attenuate risk of progression to clinical disease; and outline gaps that need to be addressed to accomplish such a trial.”
In the paper, the authors urge for collaborative global efforts to “further refine identification of at-risk individuals, formalize criteria and protocols, and identify appropriate clinical trial endpoints and potential treatments to move us closer to the goal of prevention of pulmonary fibrosis.”
Dr. Podolanczuk adds that in the paper, they highlight the importance of identification, screening, and reporting findings. “We need to make sure that radiologists are reporting [ILAs] and that those patients are being appropriately funneled into pulmonary evaluation and ideally to specialized centers like ours where they can be evaluated and enrolled in research. If we can diagnose it and treat it earlier, just like in cancer, we will have a much better option for maintaining patient's quality of life and preventing death.”
We need to make sure that radiologists are reporting [ILAs] and that those patients are being appropriately funneled into pulmonary evaluation and ideally to specialized centers like ours where they can be evaluated and enrolled in research. If we can diagnose it and treat it earlier, just like in cancer, we will have a much better option for maintaining patient's quality of life and preventing death.
— Dr. Anna Podolanczuk
Learning from Other Disease Approaches
Dr. Podolanczuk says that she looks at the approach to treating cardiovascular disease when thinking about treating ILAs, ILDs, and pulmonary fibrosis. “We don’t wait for people to get a heart attack to treat their heart disease,” says Dr. Podolanczuk. “We treat risk factors, we treat high cholesterol, and we treat high blood pressure. In similar ways, if we can identify those early risk factors for pulmonary fibrosis and treat them, we can potentially prevent disease development and progression.”
She adds that heart disease has proven drugs, like statins and blood pressure medication, that are well-tolerated. “The challenge is that we don’t have drugs like that yet in pulmonary fibrosis,” Dr. Podolanczuk says. “But there are so many clinical trials we’re doing here at NewYork-Presbyterian/




